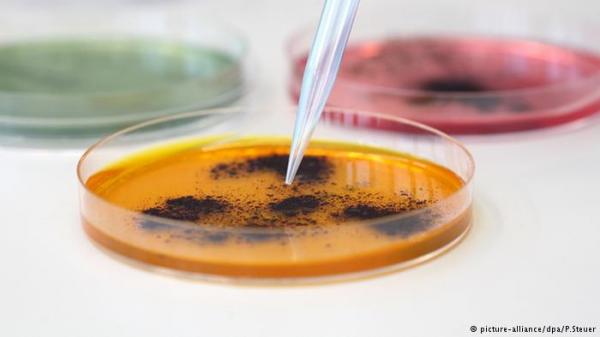
اكتشاف بكتريا مقاومة لكل المضادات في أمريكا

دويتشه فيله
أبلغ مسؤولون بالقطاع الصحي في الولايات المتحدة الخميس ( 26 أيار/ مايو 2016) عن أول حالة بالبلاد لمريضة بعدوى مقاومة لكل أنواع المضادات الحيوية وعبروا عن قلقهم الشديد من أن ما يطلق عليها البكتيريا القاتلة قد تشكل خطرا كبيرا بالنسبة لأنواع العدوى المعتادة في حال انتشارها.
وقال توماس فريدن مدير المراكز الأمريكية لمكافحة الأمراض والوقاية منها "نواجه خطورة الدخول في عالم ما بعد المضادات الحيوية" في إشارة إلى عدوى بالجهاز البولي لامرأة في بنسلفانيا تبلغ من العمر 49 عاما ولم تسافر خلال الأشهر الخمسة الماضية.
وقال فريدن خلال مأدبة غداء نظمها نادي الصحافة الوطني في واشنطن العاصمة إن العدوى لم يتم السيطرة عليها حتى بعقار كوليستين وهو مضاد حيوي مخصص للاستخدام ضد ما يطلق عليها "البكتيريا الكابوس".
وورد ذكر الإصابة الخميس في دراسة بدورية تابعة للجمعية الأمريكية لعلم الأحياء المجهري. وقالت الدراسة إن البكتيريا نفسها أصيبت بجزء صغير من الحمض النووي يطلق عليه اسم البلازميد الذي يمر بجينوم يطلق عليه اسم إم.سي.آر-1 يمنحه مقاومة للكوليستين.
وقالت الدراسة "ينذر ذلك بظهور بكتيريا مقاومة للعقاقير على نطاق واسع." وأجرى الدراسة مركز والتر ريد الطبي العسكري. وأضافت الدراسة "حسب علمنا هذا أول بلاغ عن إم.سي.آر-1 في الولايات المتحدة." وشددت الدراسة على أهمية المراقبة المتواصلة لتحديد التكرار الفعلي للجين في الولايات المتحدة.

_1774476962.webp)




